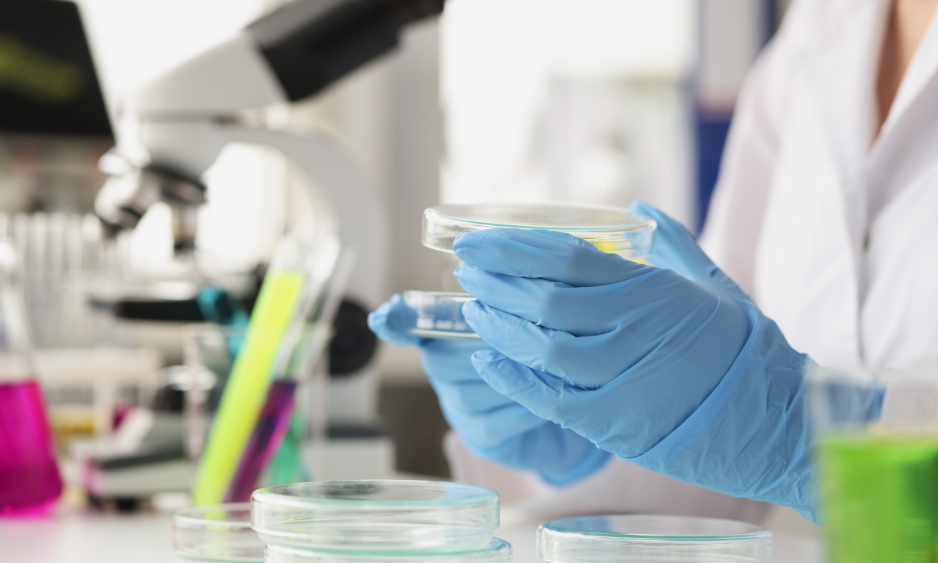

手汗がひどいと、どうなるの?

手掌多汗症は日常生活に広く影響します。
たかが手汗、と侮ってはいけません。
本記事では、具体的な日常生活への悪影響に加え、
それらの積み重ねによる「不安障害やうつ」の可能性や、
「人生の選択や性格」に与える影響について解説します。
自身が多汗症でなくとも、子どもや友人のような近しい人が多汗症である方は、
多汗症患者の気持ちを知るため、本記事を読んでいただけると幸いです。
本記事の専門的な内容は、
日本皮膚科学会が発行する「原発性局所多汗症診療ガイドライン」の記載内容をベースに、
国公立大学院卒(分子生物学専攻)のブログ管理者が作成しています。
日常生活への悪影響とは?

手のひらに大量に汗が出て、握手や筆記、スマホ操作で困るーー
手掌多汗症は、平均的に14歳で発症します。
思春期真っ只中で、性格の形成等で非常に大切な時期です。
ちなみに私は10歳ごろに発症し、
小学校高学年から社会人に至るまで、手汗に悩まされてきました。
私が経験した悩みは、以下の通りです。
手掌多汗症の皆さんは、「分かる~!!!」と思ってくれるはず。
- 学校生活と放課後

– 勉強:手汗でノートが濡れてしまい、文字を書きにくくなる。その結果、学習に集中できず、ストレスを感じる。勉強のために書くことが嫌いになる。
– 試験:手汗で試験用紙が濡れてしまい、回答を書くスピードが落ちてしまう。その結果、実力を発揮できず成績が落ちる。高校入試では、時間内に小論文を書ききれず、落ちたことを確信した。
– 部活(テニス):テニスラケットのグリップが濡れてしまい、滑って思い通り触れなくなる。途中まで優勢だった試合が、途中からグリップが滑るようになり、実力を発揮できず負けてしまう。
– 学校行事:同級生と手を繋がないといけない場面で、不快に思われてしまわないか不安になる。実際、同級生に「めっちゃ濡れてるやん!」といわれ、傷つく。
– ゲーム:コントローラーのボタンの隙間に手汗が入ってしまい、故障する。友達の家で友達のコントローラーを使うと故障させてしまうかもしれないので、遠慮する。結果、ゲームを楽しめなくなる。
- 社会人生活

– マウスとキーボードがすぐに汚れる。同僚や上司に、汚いと思われないか不安になる。
– 初対面の人と握手をする流れになったとき、不快に思われないか不安になる。
– 手書きのメモを取らないといけないとき、メモ用紙が濡れてうまく書けず、ストレスを感じる。
– 「この本、読んどきなさい」と上司から渡された本を、手汗でしわしわにしてしまわないよう気を遣いながら読む。人のものは基本的にストレスを感じる。
- 人間関係

– 友人関係:ハイタッチしたり握手したり、接触があったときに不快に思われてしまわないか不安になる。結果、ノリが悪くなってしまう。
– 恋愛:異性に不快に思われてしまわないか不安になる。実際、不快に思われてしまい、傷つく。
- その他、日常生活

– スマホ操作:手汗でスマホが誤作動を起こす。スマホゲームはできない。急いでいるときは特にイライラする。
– サイン:ホテルのチェックイン等、サインを求められるときに紙や画面が濡れてしまわないように気を遣う。濡れてしまったとき、相手の反応が気になってしまう。
ざっと思いつくだけでも、こんなにあります。
症状の程度にもよるとは思いますが、
手掌多汗症患者は四六時中、手汗に悩み、日常生活のQOL(生活の質)が低下してしまう傾向にあります。
さらに、日本皮膚科学会によると、
手掌多汗症が精神状態に与える悪影響についても明らかになってきています。
精神状態への悪影響とは?
手掌多汗症は、日常生活に広く悪影響を与えています。
こういったストレスを抱え続けている手掌多汗症患者は、
結果として、パニック障害などの不安障害や、うつの傾向が見られる事が示されています。
さらに、不安や恥ずかしさ等のネガティブな感情が原因で、
様々な活動を避けてしまうことが増えてしまいがちです。
私も、就活の際、握手が多い営業職は避けてしまいました。
また、もともと生物学専攻でしたが、
実験で使用するゴム手袋が手汗と相性が悪かったこともあり、
類似の研究職への就職も避けてしまいました。
このように、
手汗によって希望職種を断念したり、学校行事や人間関係で消極的になるなど、
人生の決断や性格にまで影響が及ぶことがあります。
治療が精神状態に及ぼす影響とは?

手掌多汗症が、日常生活だけでなく、
精神状態にも悪影響を及ぼすことがあると分かりました。
それらを解決する方法は、やはり手掌多汗症の治療です。
治療をすることで発汗量を軽減できると、
手汗による日常的な負担を減らしてQOLを向上させることができ、
さらに、精神的健康度も改善できる傾向にあることが分かっています。
より快適で快活な生活を送れるよう、治療に一歩踏み出しましょう。
具体的な治療方法は、こちらの記事にまとめています。
※もちろん、日本皮膚科学会が発行する「原発性局所多汗症診療ガイドライン」の記載内容をベースにまとめたものです。
まとめ

手汗は学校生活や社会人生活、人間関係等、
日常生活に広く悪影響を与えます。
日常生活で抱えるストレスが
結果として、パニック障害などの不安障害やうつに繋がってしまうこともあります。
また、不安や恥ずかしさ等のネガティブな感情が原因で、
希望職種を断念したり、学校行事や人間関係で消極的になるなど、
患者の人生の決断や性格にまで影響が及ぶことがあります。
でも、大丈夫。
手掌多汗症は、治療で解決できることが多い疾患です。
さらに、治療により、精神状況も改善する傾向にあります。
より快適で快活な生活を送れるよう、治療に一歩踏み出しましょう。
学生なら、両親に治療の相談をしてみましょう。
あなたの暮らしが少しでも楽になりますように。
参考資料
- 原発性局所多汗症診療ガイドライン 2023 年改訂版
